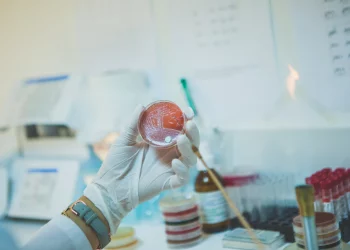

Recueil et analyse d'échantillons biologiques
L’équipe de laboratoire BEN YOUSSEF se soucient de votre santé et de celle de votre famille
Afin de mieux répondre aux attentes de nos patients et de tous nos partenaires nous mesurons régulièrement leur niveau de satisfaction.
Notre équipe reste toujours à votre entière disposition pour toute
suggestion ou besoin d'assistance.
(216) 75 627 710
(216) 75 627 711
Laboratoire BEN YOUSSEF est un laboratoire de biologie médicale. Nous vous accueillons dans un centre médical à Houmt souk sur la route touristique près de la clinique Echifa- Djerba- Tunisie. Ce complexe comprend la plupart des spécialités médicales et un centre de radiologie. Le biologiste responsable Dr ACHRAF BEN YOUSSEF et son équipe sont prêts à vous accueillir en vous garantissant une qualité de service optimale. Le plateau technique du laboratoire assure une activité de biologie polyvalente comprenant les analyses de biochimie, hématologie, hémostase, immunohématologie, sérologies bactérienne et virale, microbiologie bactérienne et parasitologie.
Le laboratoire est spécialisé aussi dans le diagnostic de l’infertilité (spermiologie, maladies sexuellement transmissibles et hormonologie appliquée à l’andrologie). Le laboratoire est équipé aussi d’une paillasse de biologie moléculaire pour l’amplification du génome du VHC, VHB, HIV, H1N1, Neisseria , Chlamydia trachomatis et Mycobactérium tuberculosis. L’activité de Biochimie est assurée par la chimie de Roche Diagnostics. L’activité d’hormonologie et de sérologie est assurée également par des automates de Roche Diagnostics et de Biomérieux. Tous nos automates sont reliés en réseau avec le logiciel du laboratoire à fin de garantir des résultats optimales et de qualité.

Laboratoire BEN YOUSSEF est un laboratoire de biologie médicale. Nous vous accueillons dans un centre médical à Houmt souk sur la route touristique près de la clinique Echifa- Djerba- Tunisie. Ce complexe comprend la plupart des spécialités médicales et un centre de radiologie.
Le biologiste responsable Dr ACHRAF BEN YOUSSEF et son équipe sont prêts à vous accueillir en vous garantissant une qualité de service optimale.
Du Lundi au dimanche : De 7h:00 à 19h:00
© Copyright Laboratoire BEN YOUSSEF 2021. Réalisé par l’agence web ONETEAM